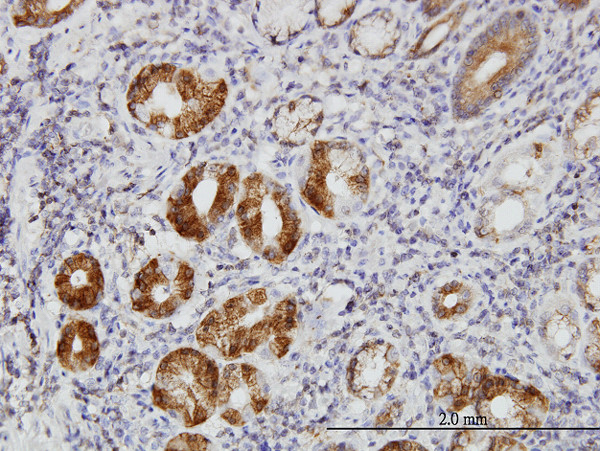
TLN1 Antibody in Immunohistochemistry (Paraffin) (IHC (P))

Search
Abnova
TLN1 Monoclonal Antibody (5C1)
{{$productOrderCtrl.translations['antibody.pdp.commerceCard.promotion.promotions']}}
{{$productOrderCtrl.translations['antibody.pdp.commerceCard.promotion.viewpromo']}}
{{$productOrderCtrl.translations['antibody.pdp.commerceCard.promotion.promocode']}}: {{promo.promoCode}} {{promo.promoTitle}} {{promo.promoDescription}}. {{$productOrderCtrl.translations['antibody.pdp.commerceCard.promotion.learnmore']}}
产品信息
H00007094-M05
种属反应
宿主/亚型
分类
类型
克隆号
抗原
偶联物
形式
浓度
纯化类型
保存液
内含物
保存条件
运输条件
产品详细信息
Sequence of this protein is as follows: SALSVVQNLE KDLQEVKAAA RDGKLKPLPG ETMEKCTQDL GNSTKAVSSA IAQLLGEVAQ GNENYAGIAA RDVAGGLRSL AQAARGVAAL TSDPAVQA
靶标信息
Talin, a multifunctional constituent of cell-substratum attachment sites, is a high molecular weight protein (225-235 kDa) found in variety of tissues and cell types. It is localized at a subset of adherens junctions, specialized cell-cell and cell-matrix associations that are characterized by the presence of filamentous actin at the cytoplasmic face of the junctional complex. In cultured cells, talin is absent from cell-cell junctions and found predominantly at adhesion plaques and in fibrillar streaks underlying cell surface fibronectin. Talin interacts with at least two other proteins that are localized at adhesion plaques, vinculin and integrin.
仅用于科研。不用于诊断过程。未经明确授权不得转售。
篇参考文献 (0)
生物信息学
蛋白别名: Talin-1
基因别名: ILWEQ; KIAA1027; TLN; TLN1
UniProt ID: (Human) Q9NZQ2, (Mouse) P26039
Entrez Gene ID: (Human) 7094, (Rat) 313494, (Mouse) 21894